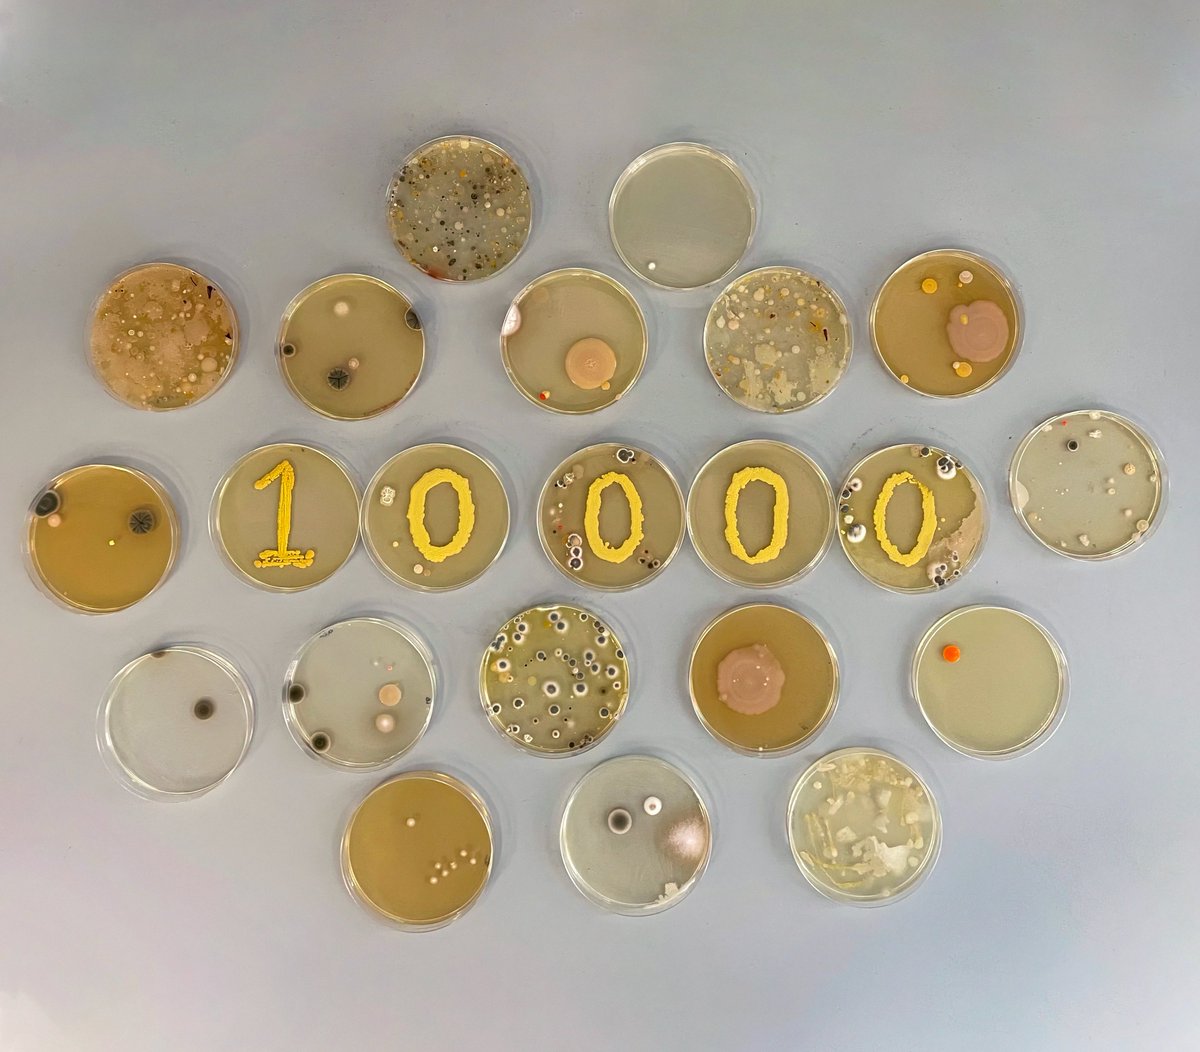
Celebrating 10,000 followers! 🎉

Thank you to everyone who enjoys looking at contaminants as much as we do - keep sharing your contams! 🦠🧫🍄🎊

Freya Allen
@freyaallen__
@MIBTP1 PhD student | AMR and enterococci | @IMIBirmingham | she/her
ID: 1354847024814952457
28-01-2021 17:41:42
44 Tweet
220 Followers
258 Following



Very excited to be attending CoCoMad '23 Cotteridge Park this Saturday representing IMIBirmingham 🧫Come and say hi to our team Rob Moran Dr Lilly Cummins Freya Allen Dr Ross McInnes Izzie Potterill



We're about to start sharing photos of everyone's plates from #CoCoMAD ! 🧫🧫 Our plate photo studio is set up here at IMIBirmingham , and we'll be posting throughout today - keep an eye out for your number!

Excited for this year’s National AMR training at University of Bristol! Come say hi at poster 73 #AMRtraining National PhD Training Programme in AMR





🔔New Pre-print🔔 TL;DR: The opportunistic pathogen A. lwoffii is more constrained in acquiring & developing antibiotic resistance 🦠 Jessica Blair Rob Moran Freya Harrison @babs_clough Dr Ross McInnes Dr Eva Frickel Mark Webber biorxiv.org/content/10.110…

Very happy have this out! I’ve been working on a couple of projects since joining @alanmcn1 and this is one of them - looking at the transcriptional response to multidrug resistance plasmids in E. coli. Thanks Ann Snaith for the help on this too! journals.asm.org/doi/10.1128/ms…







Back in Birmingham after a great month away at the University of Bonn in the Bierbaum group learning about protein purification and activity testing of WalK. Really grateful to the Bierbaum group for all their help and the Turing Scheme UK for funding this visit!